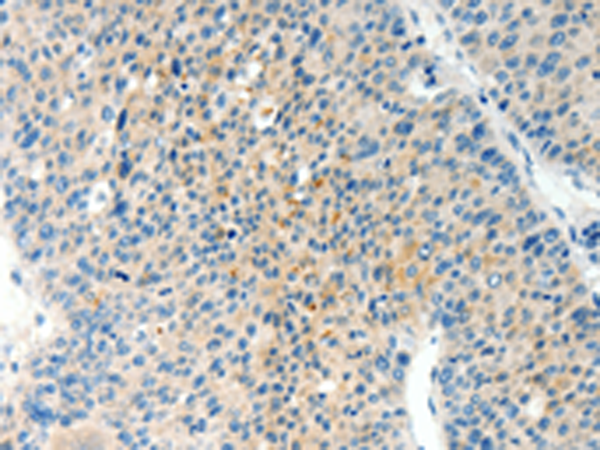

|
Background: |
This gene encodes beta-tropomyosin, a member of the actin filament binding protein family, and mainly expressed in slow, type 1 muscle fibers. Mutations in this gene can alter the expression of other sarcomeric tropomyosin proteins, and cause cap disease, nemaline myopathy and distal arthrogryposis syndromes. Alternatively spliced transcript variants encoding different isoforms have been found for this gene. |
|
Applications: |
ELISA, WB, IHC |
|
Name of antibody: |
TPM2 |
|
Immunogen: |
Synthetic peptide of human TPM2 |
|
Full name: |
Tropomyosin 2 (beta) |
|
Synonyms: |
DA1; DA2B; NEM4; TMSB; AMCD1 |
|
SwissProt: |
P07951 |
|
ELISA Recommended dilution: |
2000-10000 |
|
IHC positive control: |
Human liver cancer and Human breast cancer |
|
IHC Recommend dilution: |
25-100 |
|
WB Predicted band size: |
33 kDa |
|
WB Positive control: |
Human leiomyosarcoma and mouse testis tissue |
|
WB Recommended dilution: |
1000-5000 |
購物車
幫助
021-54845833/15800441009
